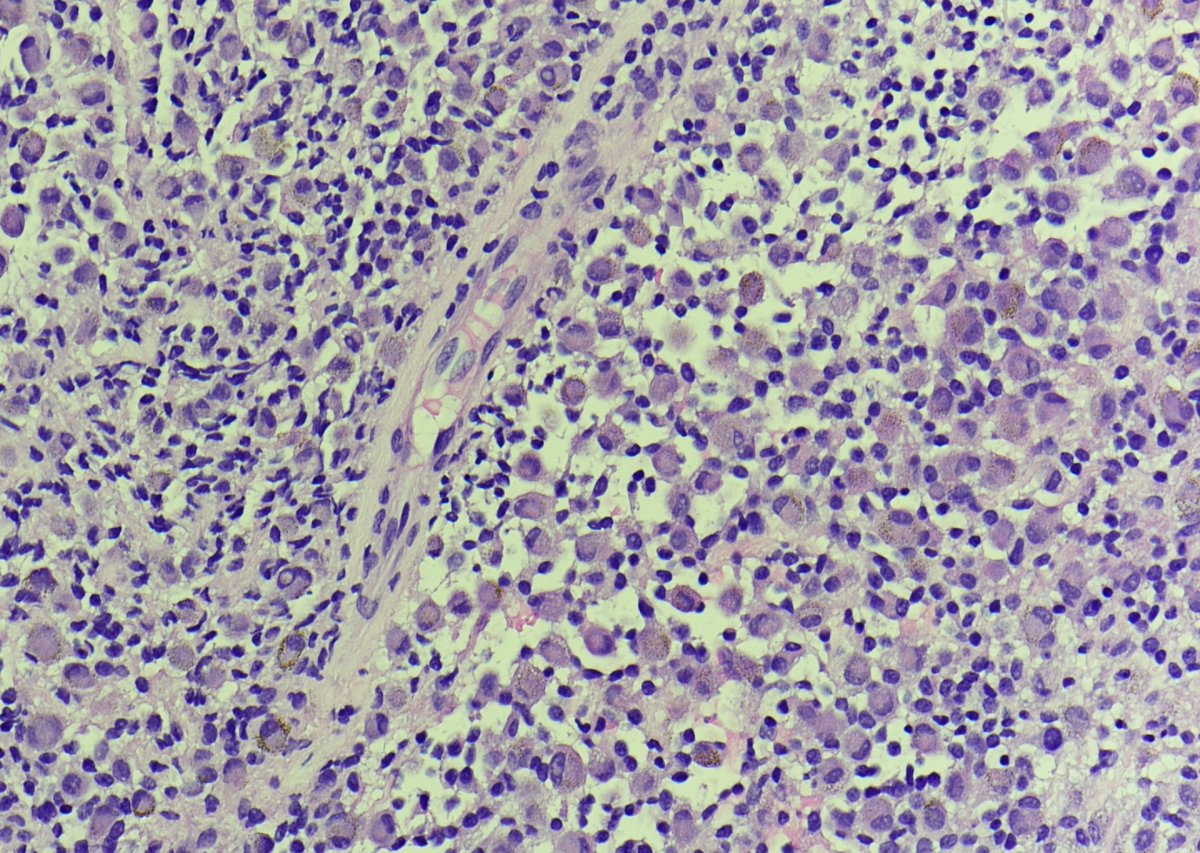
BST Path Education tweet media

BST Path Education
61 posts

BST Path Education
@PathBst
All things bone and soft tissue pathology, here to help spread knowledge to the masses.
Katılım Temmuz 2022
1.3K Takip Edilen1.1K Takipçiler

Outstanding work
Greg Charville@Greg_Charville
This is "cutaneous" syncytial myoepithelioma...of bone! @JMcMahonG with @SintawatWang recognized that these morphologically distinctive tumors occur in diverse anatomic locations, including bone. pubmed.ncbi.nlm.nih.gov/37548750/ They have recurrent EWSR1::PBX3 fusions too! #BSTpath
English
BST Path Education retweetledi


Check out the latest and greatest from @SintawatWang, @MichaelMichal28, @Greg_Charville, @JMcMahonG, published in #VirchowsArchive:
tinyurl.com/yc48rhpy
Non-cutaneous syncytial myoepitheliomas are identical to cutaneous counterparts.
Awesome!
#BSTpath #dermpath #PathTwitter
English

Oh yes. Count us in.
Maryland Society Of Pathologists@MarylandSocPath
Happy Memorial Day all! Our Summer Seminar is Sat June 3 @ 8 am EST. Bone and Soft Tissue theme. All star line-up including Dr. Khin Thway, @JMcMahonG, @AndersMeyerMD Register: marylandpathology.org/events Coming soon, don't miss out! #BSTpath #PathTwitter
English

@PathBst @AndersMeyerMD @MichaelMichal28 @kells108 @JMGardnerMD @JMcMahonG @MdSuster @Greg_Charville @mreyesm What was the fusion partner?
English


3 year old patient with history of large orbital mass, s/p chemotherapy and now resection. Diagnosis?
#pedipath #pedspath #BSTpath #BSTpatheducation #pathtwitter



English

@JMGardnerMD @kells108 @JMcMahonG @Greg_Charville @MdSuster @AndersMeyerMD @carina_dehner @MichaelMichal28 Great ideas all! Love the differentials. Agree with @GershonMD, this is tenosynovial giant cell tumor of prox thigh. Key to recognition is the larger epitheloid cells with peripheral rim of hemosiderin granules, so called ladybird cells. #BSTpath
English

Let's keep it going with back to school week. Adult patient: what is the site and diagnosis? #BSTpath #pathtwitter

English

@JMGardnerMD @kells108 @JMcMahonG @MdSuster @AndersMeyerMD @Greg_Charville @MichaelMichal28 Excellent work all! This is lipoblastoma. Clues are lobular architecture and fibrovascular septae at low power, spectrum of adipocyte maturation w/immature cells in myxoid areas, and zonal architecture with immature cells in periphery / adjacent to septae.
English
BST Path Education retweetledi

Radiolucency in frontal bone
sagittal + axial CT.
Here’s a clue: Keep a low power impression
Mild expansive remodeling, cortical thinning, radial (spoke) trabecular bone radiating around a central lucency
Diagnosis?
@reith16 @ahlawat_shivani @LauraMFayad @LisaRooperMD


Baltimore, MD 🇺🇸 English

Totally agree with @carina_dehner: this is Paget's disease. The polarized image is so perfect.
English

Was on vacay with MrsPathBst (#WorkLifeBalance), now back with this classic case: adult patient, diffuse sclerotic L1 vertebra.
#BSTpath #BSTpatheducation
(Outstanding images courtesy of @JMcMahonG)




English

@kells108 @JMGardnerMD @JMcMahonG @MichaelMichal28 @MdSuster @Greg_Charville @AndersMeyerMD Correct - clear cell chondrosarcoma, great job all!
English

40 year old man. What is the diagnosis? Can you figure out the site? Let's get those #MSKrads and #BSTpath skills to work. #BSTpatheducation
Images courtesy of @kells108




English
BST Path Education retweetledi











